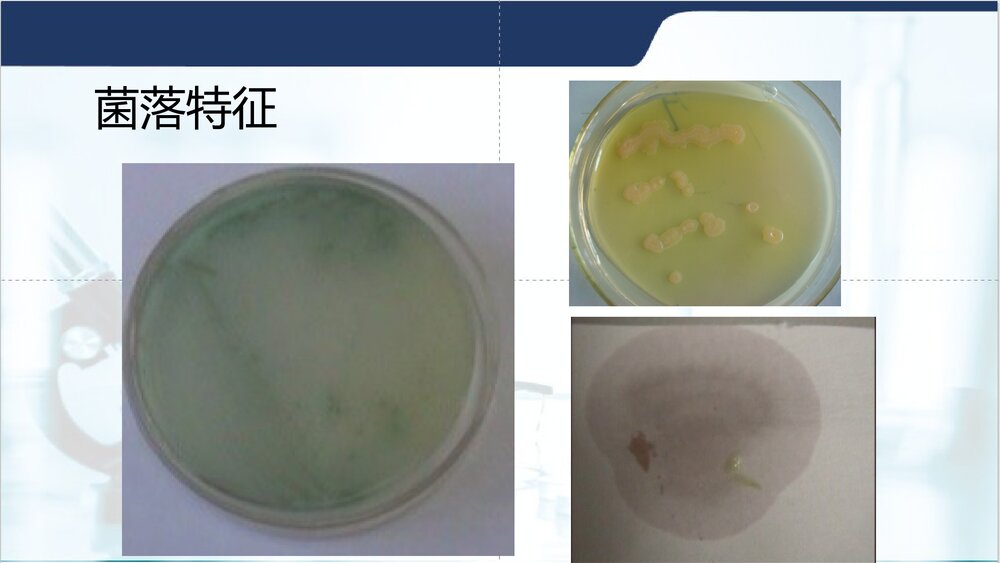
铜绿假单胞菌PPT课件下载4

铜绿假单胞菌PPT课件下载

试读已结束,还剩34页未读,您可下载完整版后进行离线阅读
文档共有44页,由于篇幅有限,只展示前10页。
铜绿假单胞菌PPT课件下载是由用户上传到202资源网,本次作品主题是PPT课件,素材大小为3.88 MB,素材总共有44页,素材格式为ppt。授权方式为VIP用户下载,成为202资源网VIP用户马上下载此素材。PPT文件完整,下载后可编辑,更多医疗疾病课件主题素材点击进入。
如需印刷成实物请先认真校稿,避免造成不必要的经济损失。
- 上一篇: 铜绿假单胞菌感染耐药性PPT课件下载
- 下一篇: 铜绿假单胞菌下呼吸道感染的治疗PPT课件下载
模板单价:¥18.00
会员免费
开通会员可免费下载任意模板
- 页数:44页
- 大小:3.88 MB
- 编号:20136
- 类型:VIP模板
- 格式:ppt
- 提示:数字产品不支持退货



















































